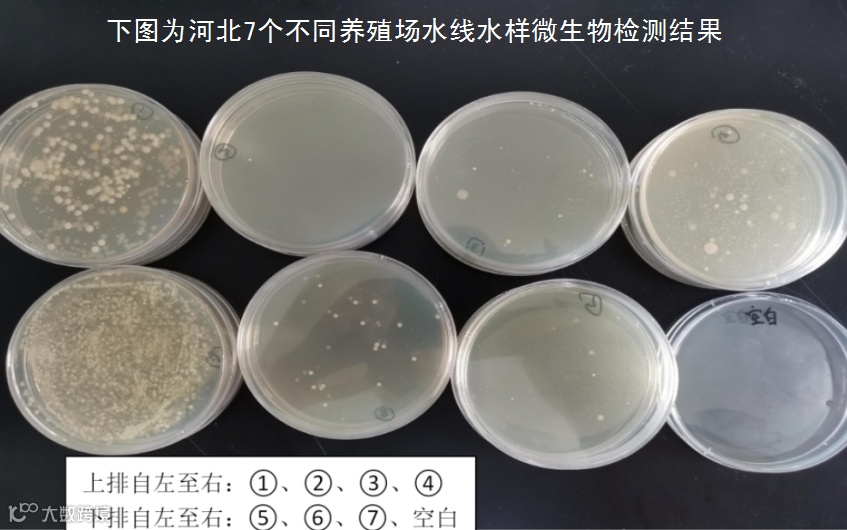

抗生素堵水线

中药堵水线



维生素类堵水线


生物制剂堵水线

解决办法



本文来自:岐黄药海拾贝,作者:四叶草。主要用于供给大家学习、交流。我们尊重原创作者和单位,支持正版。若本文侵犯了您的权益,请直接留言或电话联系我们,立刻删除!


点击
下方二维码关注我们
与|养|殖|朋|友|同|行

往期回顾
益牧堂水禽信息

抗生素堵水线

中药堵水线



维生素类堵水线


生物制剂堵水线

解决办法

本文来自:岐黄药海拾贝,作者:四叶草。主要用于供给大家学习、交流。我们尊重原创作者和单位,支持正版。若本文侵犯了您的权益,请直接留言或电话联系我们,立刻删除!


点击
下方二维码关注我们
与|养|殖|朋|友|同|行

往期回顾